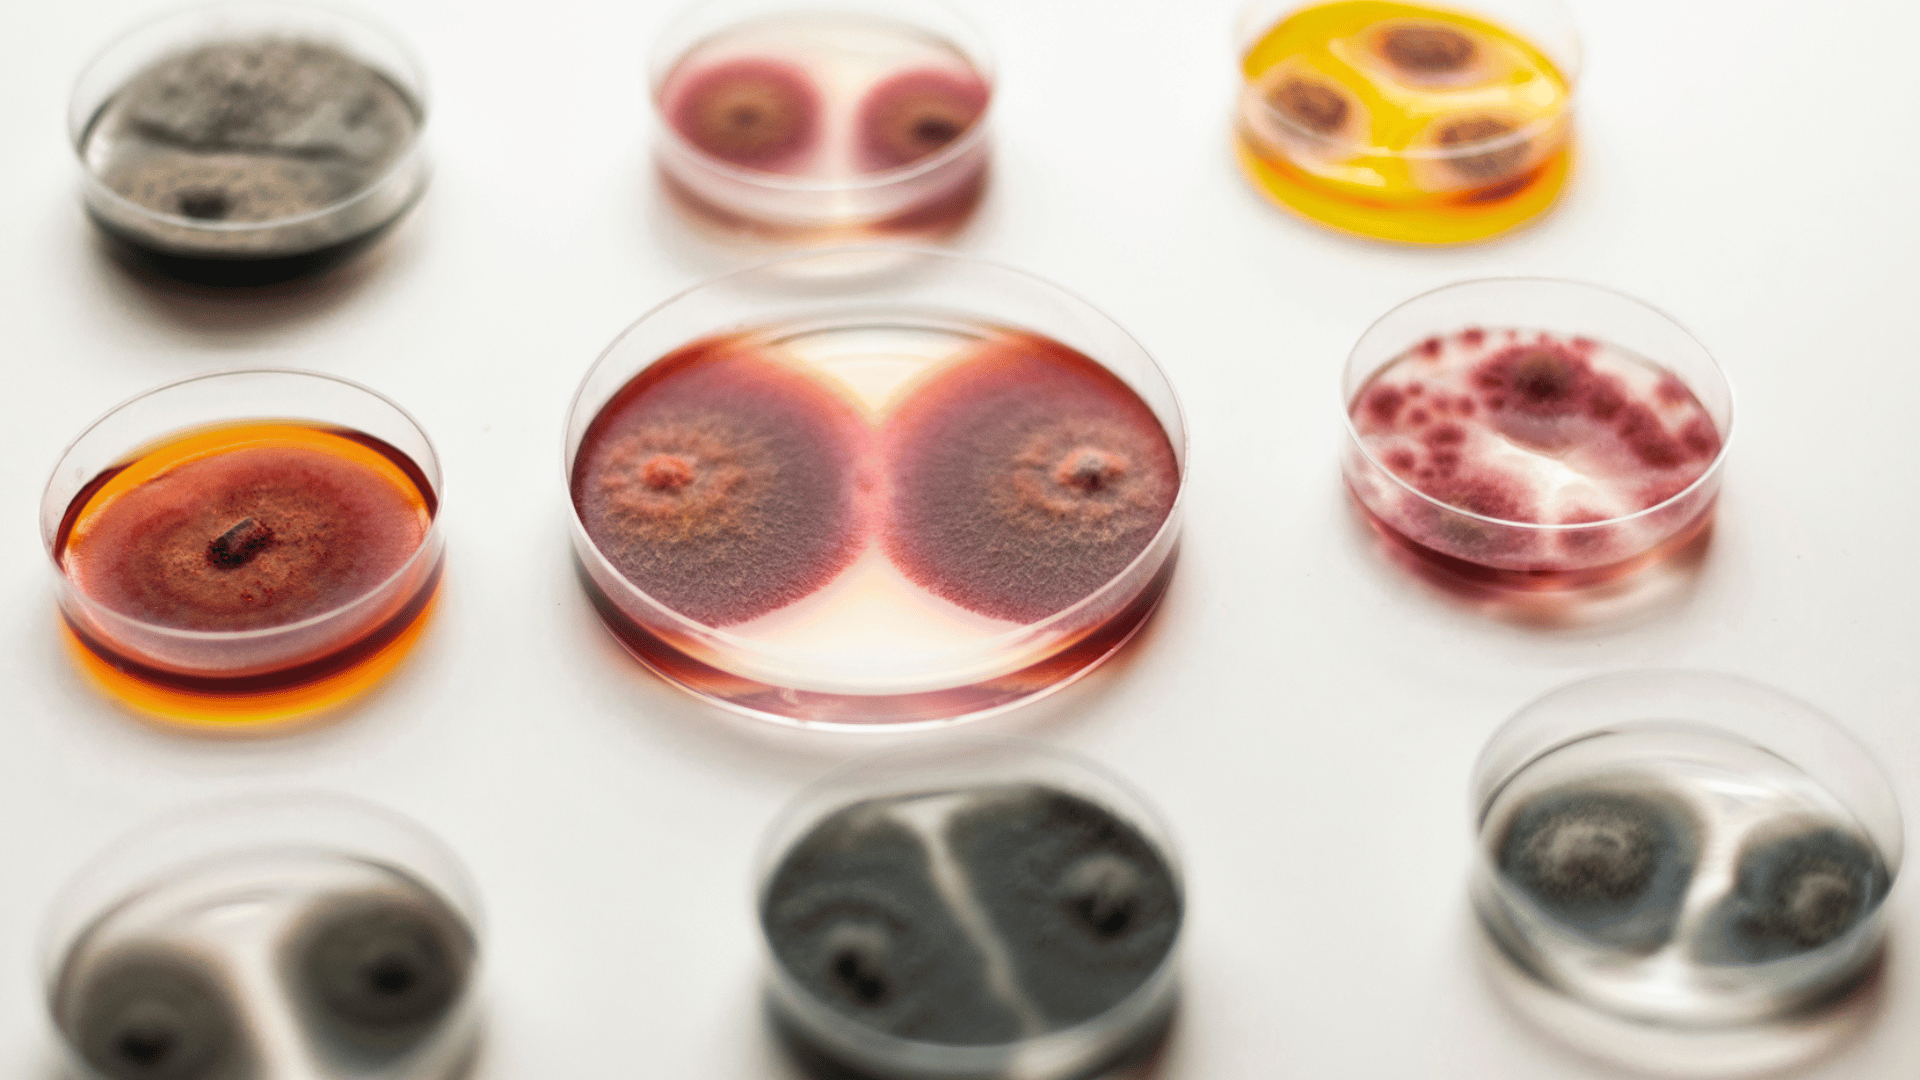
Contamination series; Photo: Selin Balci

Few practices blur the boundaries between science, nature, and creative expression as seamlessly as the work of artist Selin Balci. Her work unfolds at the microscopic scale, where mold spores, microbes, and living ecologies become “collaborators,” rather than tools or materials. In this conversation with Tomorrow’s World Today, Balci reveals how her background in forestry and microbiology shaped her unique art, which transforms invisible biological processes into colorful visual narratives.


Tomorrow’s World Today (TWT): Tell us about yourself and what inspired you to begin creating art.
Selin Balci (SB): I’m an interdisciplinary artist who works at the intersection of microbiology and contemporary art. My background is an unusual blend. I studied Forestry and spent years working in microbiology labs before completing my BFA in Photography and my MFA in Mixed Media. That scientific foundation shaped how I see the world. I became fascinated by the invisible ecologies that exist all around us and within us, and that curiosity slowly grew into a visual language. Art gave me a way to translate scientific processes into emotional, human stories, and that’s really where my practice began.
TWT: How would you describe your style as an artist?
SB: My style is rooted in bio-art and grounded in an interdisciplinary approach that merges scientific processes with traditional artmaking. I collaborate with living organisms, especially mold spores, to create works that grow, shift, and transform over time. Visually, my pieces feel organic, abstract, and textural, but conceptually, they sit at the intersection of ecology, time, decay, and the human condition.
I work with microorganisms collected from air, soil, plants, trees, and even human skin. By isolating and incubating these spores in synthetic yet habitable environments, I create living landscapes where the organisms reveal their interactions, struggles, and conflicts across the surface. As they germinate, they physically imprint their color, texture, and form onto the panels, essentially becoming a living paint agent.
My practice makes the invisible visible, bringing the unseen microbiome into the macroscopic world. The work exists where scientific observation and poetic expression meet, allowing viewers to witness the beauty and complexity of microbial life as it becomes a tangible, visual language.

TWT: What is it specifically about microbial growth that inspires your art?
Advertisement
SB: Microbial life is everywhere, yet we rarely acknowledge it. These organisms mirror our own behaviors, competition, survival, cooperation, and expansion, just on a microscopic scale. Watching mold grow is like witnessing an entire world unfolding, full of tension and beauty. The unpredictability is also deeply inspiring. I set the initial conditions, but the organisms decide the outcome, and that shared authorship is central to my work.
TWT: You use the concept of microbial organisms symbolically in your work. Could you tell us a little more about that and how it influences the subject matter of your pieces?
SB: Microorganisms are powerful symbols for me because they mirror human behavior and social structures on a microscopic level. When I watch mold spores compete, coexist, or overwhelm one another, I see reflections of our own interactions, our boundaries, tensions, vulnerabilities, and dependencies. These organisms become metaphors for identity, community, conflict, and the fragile relationships that shape our world.
Working with microbes also allows me to explore themes of visibility and invisibility. Much of what defines us, our histories, our environments, even our bodies, is shaped by forces we can’t see. By cultivating spores from specific places or people, I turn those invisible layers into tangible, observable forms. In projects like my microbial portraits, the organisms grown from a person’s own microbiome become a symbolic extension of their identity, blurring the line between self, environment, and biology.
In another project I am currently working on, microorganisms allow me to address the ecological crisis in a straightforward, tangible manner. In this installation, Eroded Landscapes: Microbial Intervention on Polaroid Memory, I again use mold spores to physically destroy Polaroid photographs, objects that, like ecosystems, are unique and unreproducible. As the spores consume the photographic layers, familiar landscapes dissolve into abstract scenes of microbial takeover. The project turns fungal growth into a metaphor for environmental decay: slow, quiet, and irreversible once it begins. By surrounding viewers with large-scale projections of this biological erosion, the installation will make ecological collapse feel intimate and unavoidable. The microbial intervention becomes a living reminder that what is lost, whether an image or an ecosystem, cannot be restored.
Ultimately, the symbolism embedded in microbial behavior guides much of my subject matter. These organisms reveal patterns of resilience, decay, and transformation that echo the conditions of our own world. As they grow, viewers are invited to confront the interconnectedness of life and the delicate, often invisible systems we depend on.


TWT: What do you find most challenging and rewarding about the mediums you work within?
SB: The most challenging part is surrendering control. Microorganisms don’t follow instructions; they grow on their own timelines, in unexpected directions. But that’s also the most rewarding part. When the work develops in ways I couldn’t predict, it becomes something alive, something collaborative. Working with living material requires patience, care, and a willingness to embrace uncertainty. The process teaches me to trust nature’s intelligence.
For more information about Selin Balci and her projects, follow her on Instagram and on selinbalci.com.



